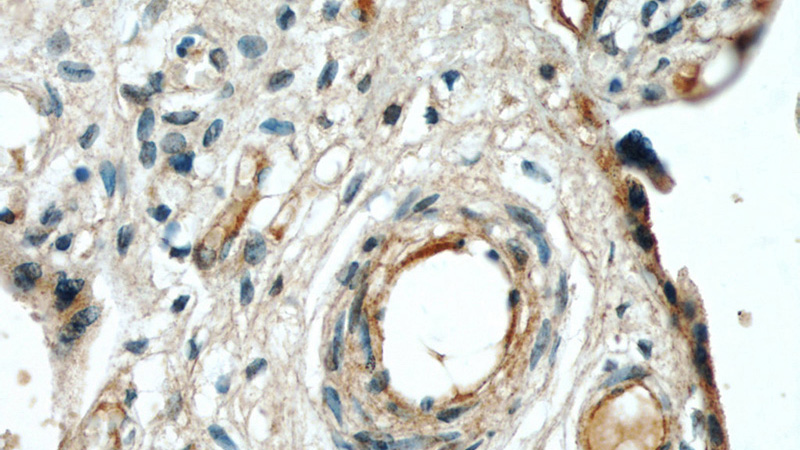
Immunohistochemical of paraffin-embedded human placenta using Catalog No:110248(ENG antibody) at dilution of 1:50 (under 40x lens)

-
Product Name
Endoglin/CD105 antibody
- Documents
-
Description
Endoglin/CD105 Rabbit Polyclonal antibody. Positive IHC detected in human placenta tissue. Positive IP detected in mouse lung tissue. Positive WB detected in mouse lung tissue. Observed molecular weight by Western-blot: 170-180 kDa
-
Tested applications
ELISA, WB, IP, IHC
-
Species reactivity
Human,Mouse,Rat; other species not tested.
-
Alternative names
CD105 antibody; END antibody; Endoglin antibody; ENG antibody; FLJ41744 antibody; HHT1 antibody; ORW antibody; ORW1 antibody
-
Isotype
Rabbit IgG
-
Preparation
This antibody was obtained by immunization of Endoglin/CD105 recombinant protein (Accession Number: NM_001114753). Purification method: Antigen affinity purified.
-
Clonality
Polyclonal
-
Formulation
PBS with 0.1% sodium azide and 50% glycerol pH 7.3.
-
Storage instructions
Store at -20℃. DO NOT ALIQUOT
-
Applications
Recommended Dilution:
WB: 1:200-1:1000
IP: 1:200-1:1000
IHC: 1:20-1:200
-
Validations

mouse lung tissue were subjected to SDS PAGE followed by western blot with Catalog No:110248(ENG antibody) at dilution of 1:300

IP Result of anti-ENG (IP:Catalog No:110248, 3ug; Detection:Catalog No:110248 1:300) with mouse lung tissue lysate 4000ug.

Immunohistochemical of paraffin-embedded human placenta using Catalog No:110248(ENG antibody) at dilution of 1:50 (under 10x lens)
Immunohistochemical of paraffin-embedded human placenta using Catalog No:110248(ENG antibody) at dilution of 1:50 (under 40x lens)
-
Background
Endoglin (ENG, CD105) is a homodimeric cell membrane glycoprotein of 180 kDa, composed of disulphide-linked subunits of 95 kDa. Endoglin is a proliferation-associated and hypoxia-inducible protein mainly expressed on vascular endothelial cells. It acts as an accessory receptor for transforming growth factor beta (TFG-β) and is involved in vascular development and remodelling. The important role of Endoglin in angiogenesis and in tumor progression makes it an ideal target for antiangiogenic therapy and a good marker for tumor prognosis. (PMID: 1326540; 14528280; 21737653; 12773481)
-
References
- Tskitishvili E, Sharentuya N, Temma-Asano K. Oxidative stress-induced S100B protein from placenta and amnion affects soluble Endoglin release from endothelial cells. Molecular human reproduction. 16(3):188-99. 2010.
- Graham N, Garrod A, Bullen P, Heazell AE. Placental expression of anti-angiogenic proteins in mirror syndrome: a case report. Placenta. 33(6):528-31. 2012.
- Kakigano A, Mimura K, Kanagawa T. Imbalance of angiogenic factors and avascular edematous cystic villi in a trisomy 13 pregnancy: a case report. Placenta. 34(7):628-30. 2013.
Related Products / Services
Please note: All products are "FOR RESEARCH USE ONLY AND ARE NOT INTENDED FOR DIAGNOSTIC OR THERAPEUTIC USE"
